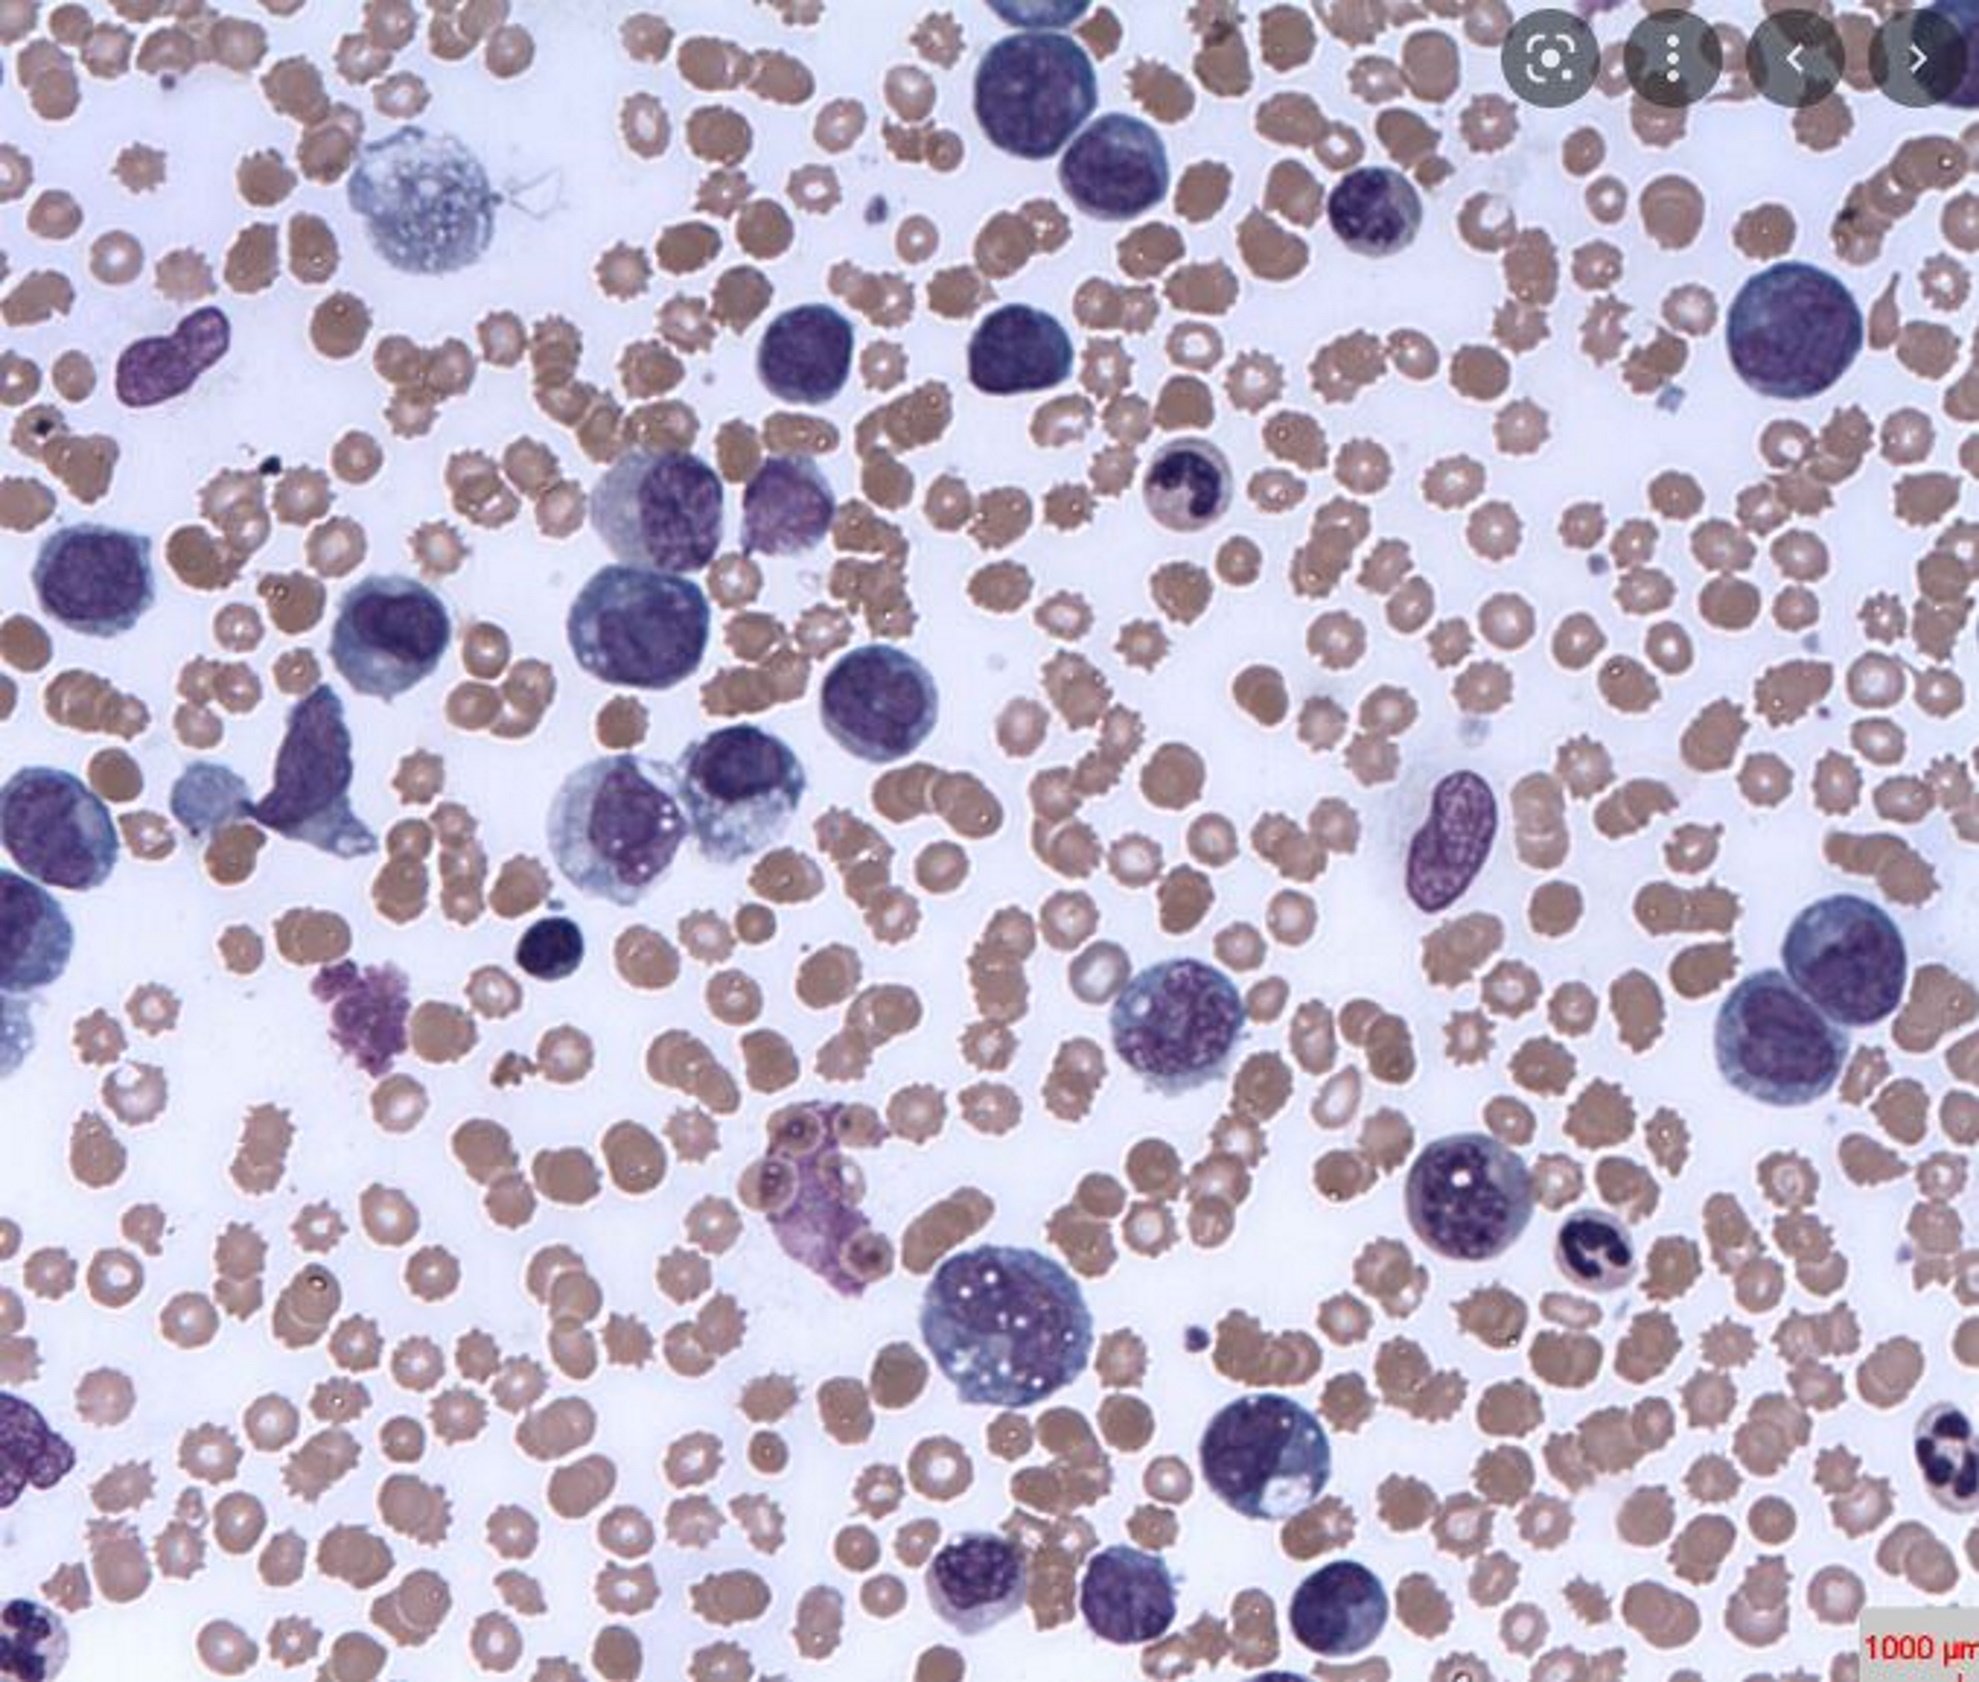
Un equip catalano-israelià troba un gran avenç per a la leucèmia

Un equip de científics catalano-israelià ha trobat un gran avenç per la leucèmia, en concret un mecanisme per fer que les cèl·lules canceroses de la sang siguin inofensives, segons informa el diari Jerusalem Post. L'equip acaba de publicar la seva recerca a la revista especialitzada Leukemia sota el títol de Remodelació del paisatge de l'ARN m6A en la conversió de cèl·lules de leucèmia limfoblàstica aguda en macròfags. El text descriu com les cèl·lules de leucèmia es converteixen en cèl·lules normals que ja no es multipliquen, si es canvien les modificacions químiques -l'anomenada epigenètica- d'un tipus del seu material genètic anomenat ARN missatger.
"Sabem que una estratègia que tenen els tumors humans per esquivar l'eficàcia dels fàrmacs és canviar la seva aparença, convertint-se en un altre càncer similar però insensible al fàrmac utilitzat", ha indicat l'equip. "Per exemple, les leucèmies de la soca limfoide es canvien a la soca mieloide per escapar del tractament". Aquesta línia d'investigació encara no s'ha provat en pacients, però els investigadors asseguren que sembla força prometedora i que val la pena explorar-la com a nou enfocament en la lluita contra la leucèmia. "Els primers fàrmacs preclínics amb aquest objectiu ja s'han desenvolupat en models experimentals de malalties malignes de la sang, de manera que proporcionem una altra raó per la qual aquests nous fàrmacs podrien ser útils en teràpies contra el càncer, especialment en el cas de leucèmies i limfomes", ha indicat un dels investigadors.
Entre l'equip català hi ha Alberto Bueno-Costa, investigador del grup del doctor Manel Esteller, que dirigeix l'Institut de Recerca de la Leucèmia Josep Carreras de la Universitat de Barcelona. I per part israeliana hi ha els professors Gideon Rehavi, Nitzan Kol, Chen Avrahami i Sharon Moshitch-Moshkovitz, del Departament de Genètica Humana i Bioquímica de la Facultat de Medicina Sackler de la Universitat de Tel Aviv.
La leucèmia és una proliferació incontrolada d'una població anòmala de cèl·lules de la sang. Aquestes cèl·lules anòmales infiltren la medul·la òssia i impedeixen la producció de les cèl·lules normals restants, i envaeixen la sang i altres òrgans. També és la forma de càncer més freqüent en els nens: 1 de cada 3 nens amb càncer té leucèmia. Actualment la quimioteràpia és l’eix fonamental en el tractament de les leucèmies. Algunes característiques en el moment del diagnòstic permeten determinar la intensitat necessària del tractament i establir un pronòstic adequat, com ara l’edat, el recompte inicial dels glòbuls blancs, l’afectació del sistema nerviós i les anàlisis específiques (citogenètic i estudis de biologia moleculars).